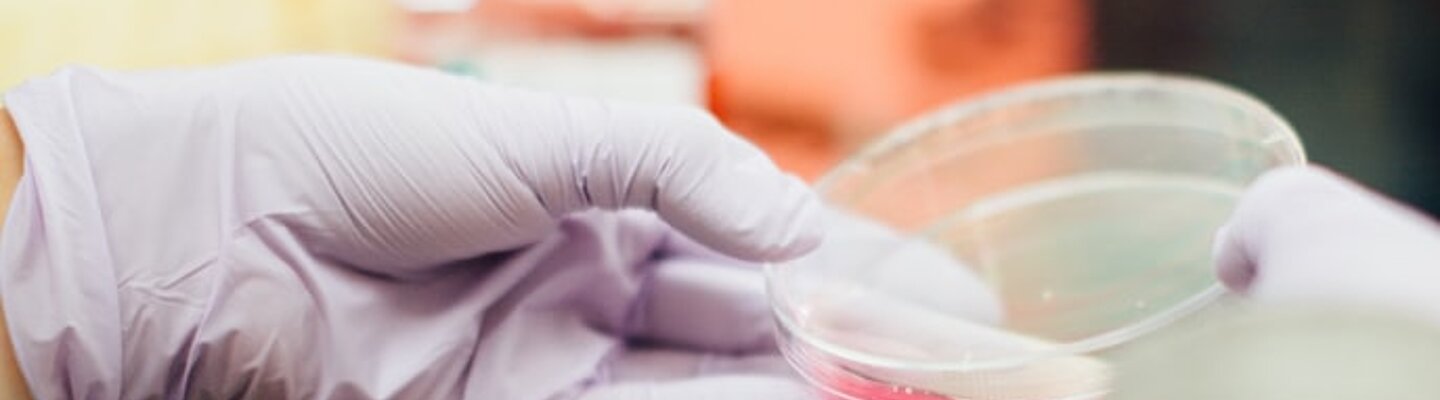

Controle Bacteriano Utilizando Bacteriófagos
O desenvolvimento de métodos alternativos de controle microbiano se torna cada vez mais necessário devido ao crescente aumento da ocorrência de bactérias resistentes aos antibióticos. A utilização da bacteriófagos se destaca por permitir a redução da espécie alvo de forma altamente específica. Essa característica é desejável já que espécies benéficas expostas a este agente biológico não são afetadas. Os bacteriófagos são utilizados em vários países e têm amplo potencial de aplicação em áreas que vão desde o tratamento de infecções até a prevenção de contaminação em produtos alimentícios.
![Instituto Presbiteriano Mackenzie [Instituto Presbiteriano Mackenzie]](/fileadmin/CONFIGURACOES/DEFAULT_21/Resources/Public/Template/img/logo/mackenzie_w.svg)



